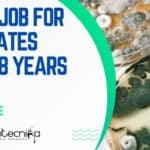
Pfizer Microbiology Vacancy 2022

Home Search
microbiology - search results
If you're not happy with the results, please do another search
Pfizer Job For Candidates With 0-8 Years Exp – Apply Online
Pfizer Microbiology Vacancy 2022 - Candidates With Minimal Exp Can Apply
Pfizer Microbiology Vacancy 2022 - Candidates With Minimal Exp Can Apply. Pfizer is hiring...
Biotecnika Times Newsletter 21.09.2022 NCCS Project Training, CCMB Jobs, CSIR NET Aarambh Batch Launch
Biotecnika Times - NCCS Project Training, CCMB Jobs, CSIR NET Aarambh
NCCS Project Training Programme 2023 In Biological Sciences, 6 Months & 1 Year Sessions...
M.Tech in Biomolecular Engineering & Biotechnology (BEBT) AND Post Graduate Certificate Program In Medical...
RGPV Admissions 2022-23 - MTech & PGCMB Admission 2022-23
Online applications in the prescribed format are invited from eligible candidates for admission in M.Tech Biomolecular...
Biotecnika Times Newsletter 20.09.2022 C-CAMP Jobs, CFTRI, IMTECH, Amway
Biotecnika Times - C-CAMP Jobs, CFTRI, IMTECH, Amway, Genpact, Unilever
C-CAMP BSc Biotech & Life Sciences Intellectual Property Specialist Recruitment
C-CAMP BSc Biotech & Life Sciences...
Decode Age Bioinformatician Job For MSc, BTech & MTech – Apply Online
Decode Age Bioinformatician Job For MSc, BTech & MTech - Apply Online
Decode Age Bioinformatician Job For MSc, BTech & MTech - Apply Online. We...
Biotecnika Times Newsletter 19.09.2022 ICMR JRF 2022 Admit Card Download, Govt CCRS
Biotecnika Times - ICMR JRF 2022 Admit Card Download, Govt CCRS
Ministry of AYUSH Govt CCRS Siddha Central Research Institute Research Fellow Recruitment
Govt CCRS JRF...
JNCASR PhD Biological Sciences Research Associate Job Recruitment
JNCASR PhD Biological Sciences Research Associate Job Recruitment
JNCASR PhD Biological Sciences Research Associate Job Recruitment. Research Associate position at JNCASR. JNCASR Research jobs for...
NIT Rourkela MSc & MTech Life Sciences Research Fellow Recruitment
NIT Rourkela Job Opening For MSc & MTech, Applications Invited
NIT Rourkela Job Opening For MSc & MTech, Applications Invited. MSc & MTech Biotech, Life...
Biotecnika Times Newsletter 16.09.2022 IISc Jobs, Govt CSRTI, HPSC Hiring, CFTRI
Biotecnika Times Newsletter IISc Jobs, Govt CSRTI, HPSC Hiring, CFTRI
IISc-MCBL MSc & PhD Biotech, Life Sciences Project Vacancies, Applications Invited
IISc Project Jobs 2022 For...
IISc-MCBL MSc & PhD Biotech, Life Sciences Project Vacancies, Applications Invited
IISc Project Jobs 2022 For MSc & PhD Biotech, Life Sciences
IISc Project Jobs 2022 For MSc & PhD Biotech, Life Sciences. Indian Institute of...
Biotecnika Times Newsletter 15.09.2022 CCMB Admissions 2023, NIBMG, IMTECH
Biotecnika Times Newsletter CCMB Admissions 2023, NIBMG, IMTECH
CCMB January 2023 PhD Program Admission – Online Application Process
CCMB PhD Admission 2023 January – Apply Online....
Panjab University MSc & MTech Life Sciences Project Assistant Recruitment
Panjab University Project Vacancy For MSc & MTech Life Sciences
Panjab University Project Vacancy For MSc & MTech Life Sciences. Candidates with MSc & MTech Biotechnology,...
TERI Project Job For MSc & MTech – 0-2 Exp Candidates Apply
TERI Project Job For MSc & MTech - 0-2 Exp Candidates Apply
TERI Project Job For MSc & MTech - 0-2 Exp Candidates Apply. Interested...
Biotecnika Times Newsletter 14.09.2022 Govt BCIL, NABI, ILS Jobs, Army School Recruitment
Biotecnika Times Newsletter Govt BCIL, NABI, ILS Jobs, Army School Recruitment
Govt Biotech Consortium India Limited Biotech & Life Sciences Jobs With Up To Rs....
NABI Research & Project Jobs For MSc, BTech, MTech & PhD – Attend Walk-In
NABI Job Openings 2022 For MSc, BTech, MTech & PhD
NABI Job Openings 2022 For MSc, BTech, MTech & PhD. NABI Project Assistant & Research...